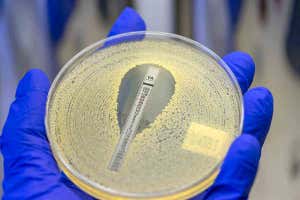
Antibiotic resistance

Ketamine has been used as an anaesthetic since the 1960s, but more recently, it has attracted attention as a potential treatment for depression and addictions.
It works by blocking NMDA receptors in the brain, which mediate the effects of a chemical called glutamate. Although many know it as a “horse tranquiliser”, ketamine is also commonly used to relieve pain in humans, particularly in children. Rather than simply blocking pain receptors, as opiates do, its strong psychological effects shift your attention away from a painful injury. These effects are short-lived, allowing a paediatrician to reset a dislocated shoulder and send a child home quite safely. It is less likely to affect the heart and breathing than other anaesthetics.
The drug induces a feeling of profound disconnection with the outside world, as well as distortions of space and time. These peculiar, psychedelic sensations make ketamine popular as a recreational drug.
However, ketamine is not without risks. If users take too much, they can fall into a zoned-out, unresponsive state, called a K-hole. They may fall unconscious or put themselves in danger.
Advertisement
Sustained use can cause bladder problems, including incontinence and severe pain. It can be addictive, and regular users may find themselves upping their dose to achieve the desired effects.
Nevertheless, ketamine may have enormous value in psychiatry. Unlike established antidepressants, which take weeks of daily medication to have an effect, an infusion of ketamine seems to relieve depression straight away, and does not need to be taken so often. In 2019, a nasal spray of a form of ketamine called esketamine was approved by the US Food and Drug Administration.
Why it works is still unclear, but it may guide us towards a new understanding of depression. The dominant idea since the 1960s has been that the condition is caused by an impaired serotonin system in the brain. But drugs designed to correct this do not work for a large proportion of patients. An alternative idea is that depression affects the structure of neurons, and glutamate helps to repair the damage. By blocking its receptors, ketamine might result in higher levels of glutamate in synapses – the gaps between neurons. Sam Wong